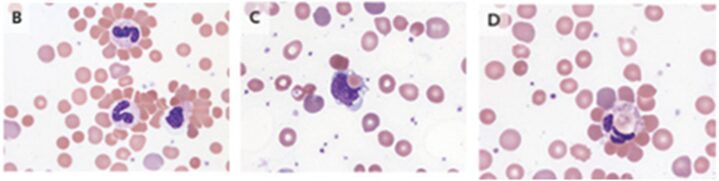

- 2025年10月7日
- 2025年12月22日
寒冷凝集素症(上気道感染症由来)
3歳女児。1週間前に上気道感染症を発症した後、1日間にわたり暗褐色尿と黄疸が出現し受診。
身体診察では、眼瞼結膜は蒼白、眼球結膜は黄染を認めた。咽頭は発赤し浸出液を伴っていた。
肝脾腫認めず。発疹認めず。チアノーゼ認めず。
採血所見では貧血と溶血を認めた。
末梢血の塗抹標本。網状赤血球(矢印)と球状赤血球(矢印)を含むさまざまなサイズの形状の赤血球および赤血球の凝集(*)が存在した。

多くの好中球は凝集した赤血球で覆われ、ロゼットを形成していた(B)
マクロファージ(C)および好中球(D)の赤血球の貪食像も見られた。
上記所見は自己免疫性溶血性貧血では稀な所見であった。
特殊採血では、直接Coombs試験は陽性、寒冷凝集素力価は1:1024だった。
マイコプラズマ、EBVを含めた一般的な呼吸器ウイルスパネル検査は陰性だった。
以上より、「上気道感染症に伴う寒冷凝集素症」と診断された。
輸血による支持療法が施行された。
3週間後には改善を認め、退院となった。
N Engl J Med 2023; 389:642
DOI: 10.1056/NEJMicm2216628
柏五味歯科内科リウマチクリニック
ホームページ